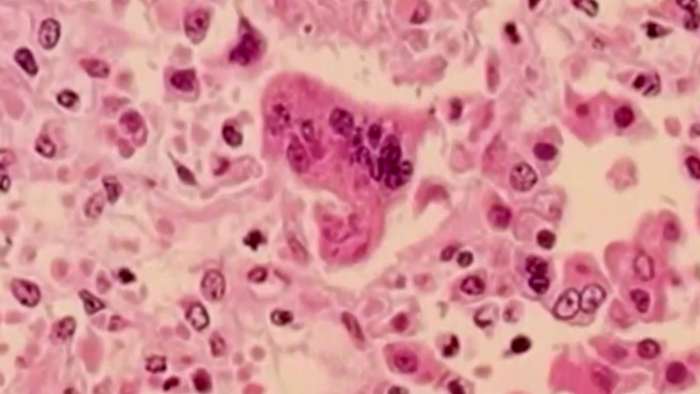

WASHTENAW COUNTY, Mich. – Lead Michigan health officials confirmed three measles cases in Washtenaw County and urged residents to check their vaccination status as the state sees more cases linked to a nationwide rise.
Public health experts say the 2025 surge in measles cases has continued into 2026, and that the virus’s high transmissibility makes widespread spread likely without strong vaccination coverage.
When asked about the three cases, Michigan Chief Medical Executive Dr. Natasha Bagdasarian gave her synopsis about the current outbreak.
“Well, unfortunately, this is something we’ve been preparing for, and this is not entirely unexpected. In 2025, we saw a record-breaking year for measles, the highest number of cases and the highest number of deaths since 1992. So when we had so many cases last year, it is expected. And what we’re seeing that those cases and those outbreaks are continuing into 2026. Looks even worse than 2025 was. We’ve already, just in the first three months of the year, seen over 1,400 cases of measles, many of those associated with large outbreaks, like the one in South Carolina, the one in Florida, the one in Utah. And we know that because measles is so incredibly transmissible, that it will spread. There is no keeping this contained in a single state or in a few states. Because this is the most communicable disease that we deal with in the infectious disease world. And it’s in fact transmissible even before people get that characteristic rash that they expect with measles. So this is not entirely unexpected, unfortunately.”
Michigan Chief Medical Executive Dr. Natasha Bagdasarian
State and local health officials confirmed a measles outbreak in Washtenaw County on Thursday, following the identification of three related cases.
Three connected cases have been reported in Washtenaw County since March 11, according to a release from the Michigan Department of Health and Human Services. An outbreak is defined as three or more connected cases.
Officials said there are currently no new public exposure sites in Michigan. You can find a list of the previous exposure sites at the end of this article.
–> Measles outbreak confirmed in Washtenaw County — Here’s what to know
The county’s first reported case was tied to travel to Florida, and the additional linked infections are unvaccinated close contacts of that original case.
Health officials emphasize that an infected person can spread the virus before the classic rash appears, making early containment difficult.
Low childhood vaccination coverage in some communities increases the risk of larger outbreaks.
Local 4 learned that an incredibly safe and effective vaccine is available.
“Measles is actually, sort of our case study when it comes to a communicable disease for which we really do have almost a foolproof prevention. It is so transmissible, it causes such serious infections, but the vaccine is so incredibly good. There’s not really another disease quite like it. A single dose of the MMR vaccine gives you 93% protection. Two doses give you 97% protection. So extremely effective. And this is a vaccine that’s been around for decades. It’s a vaccine that most of us adults received when we were children. And so there is no other disease quite like measles. And for that reason, I sometimes refer to it as the canary in the coal mine. This is really telling us what could happen with other communicable diseases as our childhood immunization rates go down.”
Michigan Chief Medical Executive Dr. Natasha Bagdasarian
Officials note the measles vaccine is a live vaccine, and some groups cannot receive it: very young infants, pregnant people, and people with certain immune-suppressing conditions or treatments.
Those who cannot be vaccinated rely on high community vaccination rates to reduce risk.
The need for community immunity is just to protect people who aren’t able to get vaccinated or who have illnesses that don’t provide protection.
“So the measles vaccine, while it is so incredibly effective, it is a live vaccine. And that means that there are some people who can’t receive it. So we don’t give it to very, very young babies. We don’t get it to those under the age of six months. People who have compromised immune systems can’t perceive it. So if you’re on chemotherapy or you’ve just had an organ transplant, you can’t receive the vaccine, or your immune system may not respond. The way that it normally should. And so there are a lot of folks who are vulnerable to this illness, who simply can’t get vaccinated. And we really rely upon what you refer to as herd immunity, or community immunity, to protect those individuals. So we know that the more people are vaccinated in a community, the better protection there is to prevent a large outbreak. And we are unfortunately seeing childhood immunization rates that are dipping down. To very low numbers. So our rates of vaccination for toddlers and preschoolers for just those routine vaccinations has dipped down to around 66%. And we also know that there are certain communities around the state, certain counties, where the vaccination rates are even lower than that. And so what that means is if you are someone who’s immunocompromised or if you have a newborn, those individuals could be at high risk.”
Michigan Chief Medical Executive Dr. Natasha Bagdasarian
Health experts recommend that people check their measles, mumps, and rubella (MMR) vaccination records and consult a health care provider or a pharmacy to receive any missing doses.
The standard schedule includes a first dose around 12 months and a second dose in childhood; adults who missed doses should talk with their provider about catch-up vaccination.
When asked if there was a pitch or what people might hear about the measles getting their attention, and whether their families are protected against its spread, Bagdasarian gave a quick reminder.
“So number one, I just want to remind people that measles is out there. It’s not just in South Carolina, Utah, and Florida. It’s here in Michigan. So you could get exposed even if you are not traveling. And this is a really good time to make sure that you’re up to date with your vaccinations. The MMR vaccine is usually given at one year of age, and then a second one is given in childhood. There are some children out there who’ve missed doses. Because there are some adults out there who may have missed doses. And so this is a really good time to talk to your health care provider or go to your local pharmacy and see if you are eligible for another dose. Now, there are a couple of groups who may not know that they are at heightened risk. If you were vaccinated around 1969, it’s possible that you received a less effective form of the vaccine. And again, you can talk to your health care providers about getting another dose of that. If you were vaccinated before 1989, that was before we had the recommendation for two doses of MMR, and it’s possible you only received one dose. So again, you can talk to your healthcare provider and get vaccinated. Now, just a reminder about what this vaccine is. It’s a vaccine that’s been around since the 1960s. So millions of people have received this vaccine. Very, very safe. It does not cause autism. The benefits of getting the vaccine are far, far greater than any risks. There are some people out there who may not be eligible. As I mentioned, if you’re pregnant, for newborns, if you’re immunocompromised, you may not be eligible for the vaccine, so talk to your healthcare provider, but this is a really good time to make sure that you’ve had two doses of the MMR. And those two doses are incredibly effective at protecting you, 97% effective in preventing all forms of measles.”
Michigan Chief Medical Executive Dr. Natasha Bagdasarian
Adults and boosters: Most adults who received two doses of MMR do not need a booster.
Public health guidance recommends additional doses only for people who may have received a less effective vaccine formulation in earlier years or who received only one dose before the two-dose recommendation.
A lot of people asked health officials, even if they’re fully vaccinated, should they get a booster as an adult?
“You don’t need a booster unless you fall into one of those categories. If you received a potentially less effective form of the vaccine or if you were vaccinated before 1989, and you may have only received one dose, then you can get another, but otherwise, this vaccine is so good that it confers lifelong immunity. So the vast majority of folks who’ve been impacted by the outbreaks that we’re seeing in 2026 were unvaccinated. So getting, making sure that you’re up to date with vaccination, making sure that at some point in your life you’ve had those two doses, is the best form of protection. And I just want to remind your viewers that measles is not just a mild illness. It can cause really devastating consequences. Before we had the vaccine, every year we used to see about 50,000 people hospitalized from measles. And about 500 children die from the measles every year. It can cause pneumonia. It can cause swelling around the brain, seizures, and long-term effects like hearing loss. It can leave you vulnerable to other infections. And it can even cause death in a small number of cases. So again, the best way to stay safe and protected is to make sure that you’ve had your doses of the MMR vaccine.”
Michigan Chief Medical Executive Dr. Natasha Bagdasarian
Trust health care providers for vaccine questions.
Experts advise people to seek answers from trained medical professionals rather than relying solely on social media or unverified internet sources.
“The other point that I will just say is, there’s a lot of information out there, and sometimes that information is conflicting. Sometimes it’s hard to know who to trust. And I really advise folks who have questions about measles, who have questions about vaccines, the MMR vaccine, or any other vaccine to talk to your healthcare provider, to talk to someone who has that background and training. Rather than relying on social media or internet searches.”
Michigan Chief Medical Executive Dr. Natasha Bagdasarian
Residents should check vaccine records, contact their primary health care provider or local pharmacy for catch-up vaccination, and follow local health department guidance on exposures.
People with symptoms such as high fever, cough, runny nose, red eyes, or a rash should call a health care provider before visiting to avoid exposing others.
Watch the full interview below
Copyright 2026 by WDIV ClickOnDetroit – All rights reserved.
Source link